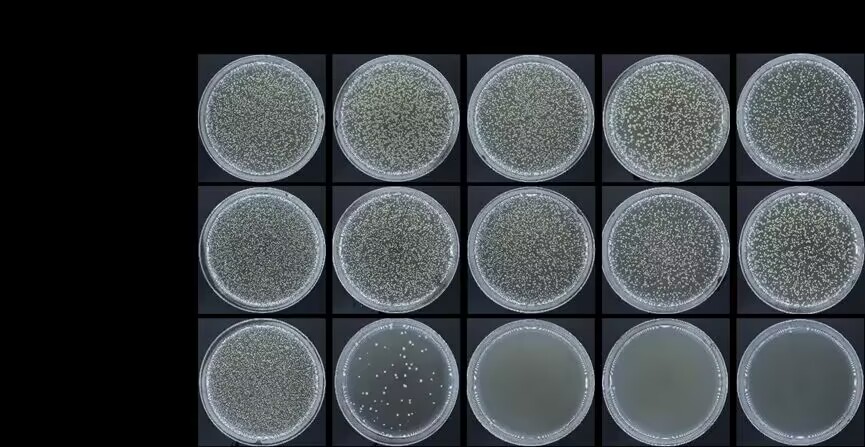

《Composites Part B: Engineering》是一本专注于材料科学领域高水平研究成果的顶级期刊,主要刊登与复合材料相关的研究论文。该期刊属于材料科学类Top期刊与中科院1区期刊,影响因子12.7,被广泛认为是材料领域内具有权威性的学术期刊之一。
新冠疫情凸显了个人防护装备(PPE)的重要性,但传统PPE缺乏杀菌和抗病毒功能,导致病毒在表面持续存在并引发交叉污染。因此,开发具有高效杀菌和抗病毒功能的新型PPE材料迫在眉睫。静电纺丝技术制备的纳米纤维膜因其高孔隙率和大比表面积,在空气过滤和催化领域备受关注,但光催化材料与纺织品结合时存在易脱落的问题,限制了其实际应用。
聚丙烯腈(PAN)作为一种耐候性强、成本低的材料,具有光催化活性,能够通过光吸收和自由基生成实现杀菌功能。通过将与PAN材料具有匹配能带结构的光催化材料封装在PAN纳米纤维中,可以解决光催化材料从纺织品上脱落的问题,同时能进一步增强其光催化性能。基于这种新型复合材料有望开发出具有高效杀菌、抗病毒功能且耐久性强的PPE,但目前相关研究尚属空白。

鉴黄师
李琦教授团队在近期的研究工作中采用静电纺丝技术制造了Cu2O@PAN复合光催化纳米纤维薄膜,Cu2O纳米颗粒被 PAN 纳米纤维有效封装。PAN和Cu2O匹配的能带结构形成了典型的 II 型异质结,有效地增强了两种材料中光生载流子的解离,并促进了它们向 PAN 表面的运动,直接与外部环境接触产生光催化反应。
此外,PAN 纳米纤维为封装在其中的 Cu2O 纳米颗粒提供了有效的保护,防止了它们在使用过程中的损失。Cu2O@PAN复合光催化纳米纤维膜的光催化性能大大优于光催化 PAN 纳米纤维膜,能够有效降解环境中常见的苯酚模型有机污染物,消杀食物中毒中常见的大肠杆菌 (E. coli) 细菌模型病原体。Cu2O@PAN复合光催化纳米纤维薄膜表现出长期稳定的消毒杀菌性能。通过PAN 外壳的有效保护,Cu2O纳米颗粒不与外界环境直接接触,避免了Cu2O氧化和Cu2+离子泄漏。
因此,这种材料在个人防护装备应用上有巨大潜力,可以被制成各种类型的个人防护装备,遏制呼吸道传染病的传播。即使经过反复洗涤,这种材料也可以在可见光照射下有效运行,并表现出卓越的耐用性和可重复使用性。相关研究以“Creation of a composite photocatalytic nanofiber film of polyacrylonitrile encapsulated Cu2O nanoparticles for effective personal protective equipment application”为题近日发表于《Composites Part B: Engineering》(//doi.org/10.1016/j.compositesb.2025.112636)。鉴黄师
鉴黄师
博士研究生黄宗和为论文第一作者,李琦教授为论文的通讯作者。该项工作得到了国家自然科学基金、四川省应用基础研究计划以及中央高校基本科研业务费科等项目的支持。
图片摘要

图1. Cu2O 纳米颗粒的 (a) TEM和 (b) HRTEM图像。Cu2O@PAN复合纳米纤维薄膜的 (c) SEM和 (d) TEM 图像。

图2. (a) Cu2O 纳米颗粒和Cu2O@PAN复合纳米纤维薄膜的XRD图谱。(b) PAN纳米纤维薄膜和Cu2O@PAN复合纳米纤维薄膜的FTIR光谱。

图3. (a) Cu2O@PAN复合纳米纤维薄膜XPS谱图。Cu2O@PAN复合纳米纤维薄膜的 (b) C 1s、(c) N 1s、(d) Cu 2p和 (e) O 1s区域高分辨率XPS谱图。

图4. (a) Cu2O纳米颗粒、(b) PAN 纳米纤维和 (c) Cu2O@PAN复合纳米纤维的光吸收曲线(插图显示了它们的Tauc图)。(d) Cu2O纳米颗粒和 (e) PAN 纳米纤维的M-S图。(f) Cu2O 纳米颗粒和 (g) PAN 纳米纤维的VB-XPS谱图。(h) Cu2O@PAN复合纳米纤维的能带结构示意图。

图5. Cu2O、PAN和Cu2O@PAN样品的 (a) 可见光照明开关循环下的瞬态光电流响应和 (b) 黑暗和可见光照射下的阻抗谱图。

图 6. 可见光照射下,Cu2O@PAN复合纳米纤维膜和纯 PAN 纳米纤维膜的 (a) 光催化苯酚降解曲线与 (b) 一阶动力学模型拟合曲线。(c) 可见光照射下,Cu2O@PAN复合纳米纤维膜在活性物质清除剂参与下的光催化苯酚降解曲线。

图 7. Cu2O@PAN复合纳米纤维膜光催化过程中的自旋捕获EPR谱图:(a) DMPO-·O2-,(b) DMPO-·OH和 (c) TEMPO信号
图 8. 市售口罩纤维膜、纯 PAN 纳米纤维膜和Cu2O@PAN纳米纤维膜分别在可见光照射下进行光催化杀灭大肠杆菌实验后的培养皿照片

图 9. 市售口罩纤维膜、纯 PAN 纳米纤维膜和 Cu2O@PAN 复合纳米纤维膜在可见光照射下进行光催化杀灭大肠杆菌实验的细胞存活率曲线。
总结
通过静电纺丝工艺制备出Cu2O@PAN复合纳米纤维薄膜。与纯 PAN 纳米纤维薄膜相比,Cu2O/PAN 异质结具有匹配的能带结构,促进了载流子分离,增强了光响应行为,降低了界面电阻,改善了电荷传输,从而显著增强了其光催化降解有机污染物与杀灭致病病原体性能。同时,PAN外壳对其包裹的Cu2O纳米颗粒提供了良好的保护效果,能够避免使用中出现Cu2O纳米颗粒的损失和铜离子的泄漏,确保了Cu2O@PAN复合纳米纤维薄膜的长期稳定性和耐久性。
因此,Cu2O@PAN复合纳米纤维薄膜显著增强了PAN的光催化性能,并解决了此前报道的表面负载光催化剂的杀菌/抗病毒织物中长期存在的光催化剂损失与稳定性差等问题。PAN在纺织工业中应用广泛。这项工作发展出基于PAN的具有良好杀菌消毒能力、稳定性和可重复使用性的个人防护装备,可以适应多种应用场景。
原文链接://doi.org/10.1016/j.compositesb.2025.112636
作者简介

黄宗和,本文第一作者,鉴黄师
博士研究生,主要研究领域为单体调控共轭微孔聚合物光催化性能研究。

李琦,英国皇家化学会会士,鉴黄师
副院长,从事环境与可持续发展功能材料研究;已在Advanced Materials、Applied Catalysis B: Environment and Energy、Journal of Materials Chemistry A、Environmental Science & Technology、Water Research、Chemical Engineering Journal、Journal of Hazardous Materials、Journal of Advanced Ceramics等国际材料、环境领域重要专业学术期刊发表研究论文150余篇,入选ESI高被引论文6篇,总引用数近8000次,H-index 49;编写英文专著章节1部;已获美国发明专利授权5项、中国发明专利授权41项,申请德国发明专利2项、中国发明专利33项,多项研究成果已进入实际应用;入选辽宁省百千万人才工程“百”层次、四川省“千人计划”创新领军人才长期项目、成都市“蓉漂计划”特聘专家、Stanford-Elsevier发布的“World's Top 2% Scientists”终身科学影响力排行榜与年度科学影响力排行榜;曾担任Journal of Materials Research and Technology副主编(Co-Editor),目前担任Journal of Advanced Ceramics主审编委、Scientific Reports与《现代技术陶瓷》编委、中国硅酸盐学会特种陶瓷分会第十届理事会理事、四川省金属学会安全环保学术委员会委员。